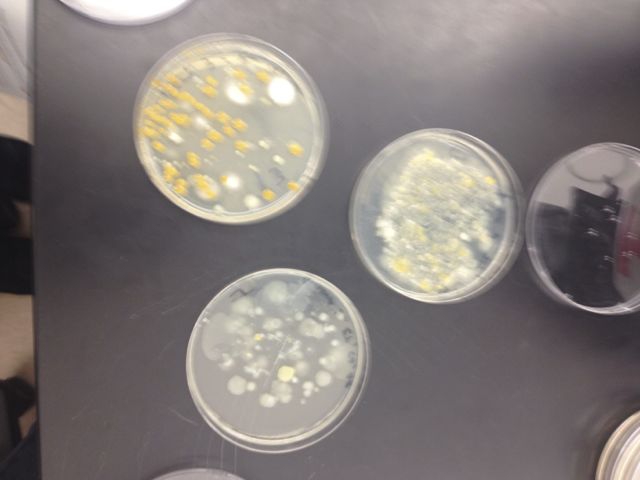

User:Karly Brinkman/Notebook/Biology 210 at AU
March 2, 2014, March 21, 2014 Lab 6 (Embryology and Zebrafish Development) Procedures
Embryogenesis Experiment with Zebrafish Larvae
Question: How will immersing zebrafish eggs in caffeinated water affect their development? In order to measure the effects of caffeine on zebrafish larvae, we compared 20 zebrafish eggs in 20 mL of tap water to 64 zebrafish eggs in 20mL of water with an additional 20 mg of caffeine. Based on reading "Movement disorder and neuromuscular change in zebrafish embryos after exposure to caffeine," a 2008 study by Tamkang University, we predicted that more zebrafish embryos/larvae exposed to caffeine would die than embryos/larvae in regular water, and that they will have shorter body lengths than their non-caffeinated counterparts.
Steps:
1) Fill two petri dishes with 20 mL of plain water.
2) Add 25mg of caffeine to one of the petri dishes and clearly label which petri dish is which.
3) Using a pipette, extract 20 zebrafish embryos and place them in the petri dish filled with water only.
4) Using a pipette, extract approximately 60 zebrafish embryos and place them in the petri dish filled with caffeine.
5) If any of the eggs are white instead of translucent, remove them (they are dead, and not useful for the experiment).
6) Examine several of the embryos (caffeinated and non-caffeinated) and use the key handed out in class to determine what stage of development they are in. Record this.
7) After four days, examine the embryos once more. Determine whether any have died, record this, and remove the dead embryos/larvae from the petri dish. Otherwise, they will grow mold.
8) Remove 42 fish from the caffeine petri dish and create a new petri dish (Caffeine 2). These zebrafish will have developed as embryos in caffeine but will grow as larvae in fresh water.
9) Record any other observations noticeable in Tables 6-8.
10) After seven days, examine the larvae. Determine whether any have died, record this, and remove them from the petri dish.
11) Examine at least one larvae from the non-caffeinated and caffeinated petri dishes. Record observations based on degree of body and tail pigmentation, eyes and eye movement, heart/heart rate, pectoral fin development, development of the swim bladder, development of the mouth, and general movement.
12) After twelve days, repeat steps 9-10.
13) After fourteen days, record final observations, remove dead fish, and dispose of remaining alive zebrafish.
Raw Data:
Day 1 Info: Control fish are at 12 hours (6-somite) and Caffeinated Fish are at 11 hours (3-somite) in terms of development.
Table 8 (Day 1 and Day 4 are same as Caffeinated Group):
Day 12 No Caffeine (Fish on left is dead, Fish on right is alive):
Conclusions: Unfortunately, a majority of our zebrafish (even the controls) died before they were supposed to, probably because of the warm temperatures of the water that sped up their growth--they ate through their embryo faster than they were supposed to. For that reason, we decided to base our results on what happened to the zebrafish after seven days, and while we collected data on day 12 and 14, that data does not go into our main conclusions about the effects of caffeine on the zebrafish. We established that the caffeine slightly stunted the growth of the zebrafish in comparison to the controls, and even the zebrafish that we extracted from the caffeine after they hatched and put in fresh water did not grow as much as the controlled zebrafish. Many times, it was not possible for us to get readings on the zebrafish heart rates, or even take measurements since they moved around very quickly (we obtained some measurements by observing the dead zebrafish). We also found that the caffeinated fish grew smaller swim bladders and were more reactive than the controlled fish in the first few days of observation. The caffeinated fish also died at a much faster rate than the control fish, as is evident by "Day 12 Caffeine (Dead)" versus "Day 12 No Caffeine (Dead)." While further research is desirable, and if this experiment was to be repeated we would better regulate the water temperature to make sure no zebrafish died from starvation, it is apparent that caffeine does have some effect on the development of zebrafish.
--KB
February 21/22, 2014 Lab 5 Information (Invertebrates) Packet Questions
Procedure 1: Observing Acoelomates, Pseudocoelomates, and Coelomates
Movements and Body Structure: The Planaria, which are acoelomates, were moving by gliding very quickly in a smooth, seamless motion. They lack a coelom so it makes sense that they are small creatures. That way, the food they ingest can pass quickly through them without being digested, since they have no system with which to do so. The pseudocoelomates that we observed in class did not move (even when I prodded them with a toothpick). I looked up a youtube video online, however, (https://www.youtube.com/watch?v=SpgjnXEFadg), and it described the Nematode's movement as whip-like. Their body-lining is not complete, which means that they do not have the necessary muscles to push themselves forwards, which is why they move in such a random fashion. Finally, the Annelids (the earthworms) moved slowly by moving their entire body forward one section at a time. As coelomates, they have the proper muscle structure to move in a controlled manner.
Size range: The organisms that we found were similar in size--between 1.5 and 2mm. The flea was the largest invertebrate that we found and the springtail was the smallest. There were lots of fleas present in the leaf litter--we found two right next to one another and another near the springtail.
Identifying Vertebrates: The five groups of vertebrates as described in the book are birds, mammals, amphibians, reptiles, and fish. I would predict that birds and mammals would be the most abundant animals in my transect. I have seen the Eastern Grey Squirrel (or Scarius carolinensis) in the transect, and I saw some birds in there as well. I am not sure of exactly what birds they were, but I would say that it is some sort of sparrow. I saw a cardinal in a nearby area on another day, so I would not be surprised if it was found in the transect. There are rats (Rattus norvegicus) all around campus, so I would also say that they would be in the transect. And the dorm buildings nearby (including mine) have had problems with mice in the past so I would say that maybe deer or field mice (or both) inhabit the transect.
Classification:
--Eastern Gray Squirrel: Phylum: Chordata, Class: Mammalia, Order: Rodentia, Family: Sciuridae, Subamily: Sciurinae, Genus: Sciurus, Species: S. carolinensis
--American Tree Sparrow: Phlyum: Chordata, Class: Aves, Order: Passeriformes, Family: Emberizidae, Genus: Spizella, Species: S. arborea
--Northern Cardinal: Phylum: Chordata, Class: Aves, Order: Passeriformes, Family: Cardinalidae, Genus: Cardinalis, Species: C. cardinalis
--Brown Rat: Phlyum: Chordata, Class: Mammalia, Order: Rodentia, Family: Muridae, Submaily: Murinae, Genus: Rattus, Species: R. norvegicus
--Meadow Vole (commonly known as field mouse): Phylum: Chordata, Class: Mammalia, Order: Rodentia, Family: Cricetidae, Genus: Microtus, Species: M. pennsylvanicus
Biotic and abiotic characteristics: Our transect is filled with plants, whose leaves would would probably serve as good food for all of the species. They would also provide shade for invertebrates that may live in the transect, which the bird species would please the birds, squirrels, rat, and mouse. The birds would also be able to dig for worms in the soil (an abiotic characteristic). Finally, the mice would serve as a good source of food for the rats.
February 21/22, 2014 Lab 5 (Invertebrates) Procedures
Procedure 1: Observing Acoelomates, Pseudoceolomates, and Coelomates
Objective: The objective of observing these three types of invertebrates was to learn more about the importance of the coelom in animal movement and gain experience observing invertebrates before analyzing the invertebrates from our transects. I predicted that the aceolomates would have the most difficult moving, followed by the pseudoceolomates, and then the ceolomates.
Steps:
1. Observe the Planaria (acoelomates) and note how it moves.
2. Mark down how the Planaria's movement relates to its lack of coelom.
3. Observe the Nematodes (pseudocoelomates) and note how it moves.
4. Mark down how the Nematodes' movement relates to their lack of a complete body cavity.
5. Observe the Annelids (coelomates) and note how they move.
6. Mark down how the Annelids' movement relates to their coelom.
Raw Data:
Conclusions: By looking at the different types of invertebrates, I discovered that the presence or lack of coelom does not necessarily make it more difficult to move, but it does affect how the invertebrates moved. My prediction was incorrect; though the Annelids were the most specialized, their movement suited their purposes just as the Planaria's movement did. If there were worms in my transect, I could have used the information I learned about coelom and apply it to the identification/study of my transect.
Procedure 2: Analyzing the Invertebrates Collected with the Berlese Funnel
Objective: The objective of this analysis was to find and identify different types of invertebrates living in my group's transect. We would do so by using the already collected samples from our Berlese Funnels, emptying them out into petri dishes, and then studying the organisms there. I suspected that any organisms we found would be very small since I had not observed any large organisms present when I collected the plant and soil sample in the previous lab.
Steps:
1. Collect the already-prepared 50:50 ethanol/water solutions--one container containing organisms floating on top of the solution, and another containing organisms that drifted to the bottom.
2. Pour out the 50:50 ethanol/water solutions into two separate petri dishes
3. Place the petri dishes under a microscope and search for organisms.
4. Once found, use the dichotomous keys and website (http://www.hope.edu/academic/biology/leaflitterarthropods/) to identify the type of organism
5. Record results in Table 5
Raw Data:
Conclusions: I identified two organisms in the petri dishes: one that I determined to be a flea and another that I determined to be a springtail. My group found a third insect, but by that time I had to hurry to complete the rest of the lab activities so I was unable to identify the insect myself. I took a picture (see Figure 14), but I do not know what organisms were under the microscope at that time. My prediction that the organisms would be very small was correct--both invertebrates were between 1.5 and 2mm. Identifying invertebrates could be useful in the future for future observations of my transect or any other experiment that involves insects. Being able to use a microscope and identify what insects are in the transect is an important skill. --KB
February 20, 2014 Lab 4 Information (Plantae and Fungi) Packet Questions
Fungi Sporangia: Fungi Sporangia are small, black structures that form on the end of hyphae. The sporangia contain cells called spores, which are important in the sporophyte or haploid phase of the alternation of generations.
"Fungi Groups:" I did not look at the fungi from my group under the microscope, but I did look at samples that had been set up at the fungi station (See Figure 9). This sample of fungi was the Rhizopus stolonifer that the packet described, with white hyphae covering the petri dish and small black sporangia.
February 20, 2014 Lab 4 Procedures (Plantae and Fungi)
Objective: The objective was to collect five plant samples from transect three in order to study the different types of plants that grow there, and take a sample of leaf litter and soil from the transect to create a Berlese Funnel so we could study invertebrates in future labs. Several questions posed to us about the vascularization, specialization, and reproduction were also important in order to be able to fill out the table and describe our own plant samples.
Steps:
1. My group went to the transect with three empty Zip-Loc bags
2. We filled one bag 80% of the way full with leaf litter and 20% of the way full with surface soil
3. We filled another bag with a sample of five different plant leaves that had fallen to the ground
4. We photographed the different plants we had taken leaves from
5. My group inserted a piece of screening material into the bottom of a funnel and then taped it so it would stay put.
6. We attached the funnel to an apparatus that would hold it up over a flask filled with 25 mL of 50:50 ethanol/water solution. It also held the funnel under a 40 watt lamp
7. We placed the leaf litter sample into the funnel, with leaves towards the bottom and a bit of soil on top
8. We covered the funnel with some foil
9. I recorded where we found each plant sample in Table 4 in the column 'Location and Number in Transect.'
10. I filled out the column 'Description (Bush, Tree, Plant) also Shape and Size, etc.' in Table 4
11. I visited the station in the lab that talked about plant vascularization (see Figure 10)
12. I filled out the column 'Vascularization' in Table 4.
13. I visited the station in the lab that talked about plant specialization (see Figure 11)
14. I filled out the column 'Leaves and Special Characteristics' in Table 4.
15. I visited the station in the lab that talked about plant reproduction
16. I filled out the column 'Seeds, Evidence of Flowers or Other Reproductive Parts' in Table 4.
17. I visited the station in the lab that talked about fungi
Raw Data:
Conclusions: We successfully collected the plant samples necessary to both make a Berlese Funnel and try to identify different types of plants in our transect. We visited the different stations and learning more about plant vascularization (xylem and phloem), plant specialization (cuticle, stomata, guard cells, parenchyma cells, mesophyll, and palisade cells), plant reproduction (gametophyte and sporophyte phases, ovary, cotyledon, monocots and dicots), and appreciating fungi (hyphae, mycelium, sporangia, spores, and rhizoids). This information gives us a better ability to understand not only plants in general, but the specific plants that grow on our transects. Furthermore, it is useful for future experiments that involve studying plants, such as if we chose to examine our Berlese Funnels for more than just invertebrates in the next week's lab. --KB
February 16, 2014 Lab 3 Information (Identifying and Studying Bacteria) Packet Questions
Archaea on agar plates? No, I do not think think that any Archaea species will have grown on the agar plates because Archaea tend to grow in extreme environments, like deep in the ocean or in hot springs or volcanoes. None of the transects at AU are located in 'extreme' environments so I expect that we will mainly find bacteria growing on the plates.
Procedure 1: Quantifying and Observing Microorganisms
Hay Infusion Culture Observations: The liquid in the hay infusion culture is a bit darker, the water level has dropped, it smells less rotten than it did before, and there is no longer a film on top of the liquid (see Figure 6). The appearance and smell is likely to change from week to week because many of the living organisms will have eaten up the dried milk so there is no longer a viable food source--therefore the remaining organisms are likely to either die out, or the heterotrophic organisms may eat each other for food. Either way, a lack of the dried milk will have affected the physical characteristics of the hay infusion culture.
Procedure 2: Antibiotic Resistance
Differences between antibiotic/non-antibiotic plates: The plates without antibiotic contained a much higher number of colonies than the plates with antibiotics--in fact, only one of the three plates with antibiotics had any colonies at all (see Table 2). This indicates that the antibiotics were largely (though not entirely) successful in killing off the bacteria.
Effect of tetracycline on bacteria/fungi: The tetracycline only allowed approximately 90 colonies of bacteria to survive, as well as a few patches of fungi.
Species of bacteria unaffected: I was unable to determine exactly how many species of bacteria are unaffected by tetracycline, but I do know that the first tetracycline-resistant bacteria was discovered in 1952 and is called Shigella dysenteriae. Since then, the number of tetracycline-resistant strains has grown in number. As of 2001, 39 gnera of gram-negative bacteria and 23 genera of gram-positive bacteria had been determined to be resistant to tetracycline (http://mmbr.asm.org/content/65/2/232.full).
How tetracycline works and what types of bacteria are sensitive to this antibiotic: Tetracycline works by blocking transfer RNA to messenger RNA in bacteria, effectively inhibiting bacterial protein synthesis. It works against gram-positive and gram-negative bacteria, including anaerobic bacteria, Rickettsiae, Chlamydia, Mycoplasma, and spirochetes. It also works against some protozoa, but is ineffective against viruses (http://www.chm.bris.ac.uk/motm/tetracycline/antimicr.htm).
*The rest of the bolded, red sections in the lab manual fit in nicely with the procedures that I have to mark down, so I will be sure to include the necessary observations, data, etc. in the next section* --KB
February 16, 2014 Lab 3 Procedures (Identifying and Studying Bacteria)
Procedures 1: Quantifying and Observing Microorganisms
Objective: The objective of the first experiment was to observe our hay culture infusions and count the number of colonies that had grown on the agar plates we had prepared the previous week. The week before I had predicted that no bacteria would grow on the agar + tetracycline plates. In addition to seeing whether that prediction was correct, I predicted that more colonies would grow on the less dilute plates.
Steps:
1. My group retrieved our hay infusion culture and observed its appearance (see Figure 6 and Hay Infusion Culture Observations in the Packet Questions above).
2. My group retrieved our agar plates and counted (to the best of our abilities) the number of colonies in each plate. We marked down the numbers counted in Table 2.
3. Using the conversion factor present in Table 2, we calculated how many colonies per milliliter were present in each agar plate.
Raw Data:
Figure 6:
Conclusions: I concluded that the most colonies of bacteria grew in the most diluted plates (according to the conversion factor) and that bacteria were able to grow in one of the tetracycline plates. My prediction about none of the bacteria being antibiotic resistant was incorrect as well as my prediction about less colonies growing on the more dilute plates. Understanding that antibiotic resistance is possible was immediately helpful to me in Procedure 2: Antibiotic Resistance, as that section focuses on the dangers of antibiotic resistance. I now have first-hand knowledge that such resistance is possible.
Procedure 2: Antibiotic Resistance
Objectives: The objective of this procedure was to observe the agar plates without tetracycline and compare them to the agar plates with tetracycline, also using Table 2 to note the differences. We were then supposed to try and determine the effect of tetracycline on the total number of bacteria and fungi, determine how many species of bacteria are unaffected by tetracycline, find out how tetracycline works, and determine the types of bacteria that are sensitive to it. By using all of our agar plates as well as consulting the internet for information on tetracycline, we determined that we should be able to answer all of the questions presented in the lab manual and make inferences about bacteria's ability to resist different types of antibiotics.
Steps:
1. I answered the first bolded question in the packet (see Lab 3 Information Packet Questions above) by comparing the agar plates with the agar + tetracycline plates as well as Table 2.
2. I answered the second bolded question in the packet (Lab 3 Information Packet Questions) by comparing the agar plates with the agar + tetracycline plates as well as Table 2.
3. I answered the third bolded question in the packet (Lab 3 Information Packet Questions) by looking up information on tetracycline and antibiotic resistance on the internet (http://mmbr.asm.org/content/65/2/232.full).
4. I answered the fourth bolded question in the packet (Lab 3 Information Packet Questions) by looking up information on how tetracycline works and the types of bacteria sensitive to this antibiotic (http://www.skintherapyletter.com/treat/rosacea/tetracycline.html and http://www.chm.bris.ac.uk/motm/tetracycline/antimicr.htm).
Raw Data:
See Figure 6 and Table 2 from Procedure 1
Conclusion:
Both from looking up information on tetracycline and observing the effects of tetracycline on the bacteria in my transect, I learned that at least one species in my transect is resistant to tetracycline. I also learned that tetracycline is an antibiotic that works by inhibiting protein synthesis in many species of bacteria, including both gram-positive and gram-negative bacteria, but resistance to this antibiotic has been increasing since the 1950s. I found it surprising and a bit disturbing that bacteria resistant to tetracycline is common enough that it exists in a plant/soil sample at American University, and I will keep this information in mind when dealing with bacteria in the future--and whenever I use hand sanitizer.
Procedure 3: Bacteria Cell Morphology Observations
Objective: The objective of Procedure 3 was to examine three of the agar plates, observing the colonies and specific cells using wet mounts and gram-staining.
Steps:
1. My group chose to analyze plates '2', '4', and 'T3.' Plates '2' and '4' were agar + nutrient plates while plate 'T3' was agar + tetracycline, and was our only tetracycline plate with bacteria growing on it. See Figure 7.
2. We began to prepare our wet mounts, making one wet mount per each plate. a) We sterilized a loop over a flame and used it to scrape up a bit of bacteria on the surface of the plate, then mixing it with a drop of water on the slide. b) We placed a cover slip over the top.
3. We also prepared a separate slide, using the same step as 2a (but without a cover slip since this is for the gram stain). We drew a red circle around the drop so we would be able to find it under the microscope.
4. We observed the wet mount under the microscope, first observing the plates at 40x objective, and then placing a drop of oil over the lens as we moved to 100x oil objective lens.
5. I recorded my observations of the three plates in Table 3, including the colony description, number of colonies per mL of culture, and cell description. I also sketched what I saw under each lens, and at what magnification I saw it (Figure 8).
6. After labeling the three slides prepared for gram-staining, we passed each slide through a flame three times with the bacterial smear side up.
7. After covering the slides with crystal violet for one minute, we rinsed them off with water-filled wash bottle.
8. We then covered the slides with Gram's iodine mordant for one minute.
9. After rinsing off the Gram's iodine mordant, we decolorized the smear with 95% alcohol for 20 seconds, stopping when the solvent flowed colorlessly from the slide.
10. We covered the smears on the three slides with safranin stain for 20-30 seconds, then rinsed it and blotted it with a paper towel.
11. We focused the gram stain at 40x magnification and then used a drop of oil on the microscope lens to observe it at 100x.
12. I marked my observations of the cell's quality (gram-positive or negative) in Table 3.
Raw Data:
Note: the plate at the top of the picture is plate '2,' the plate towards the right is plate '4,' and the plate towards the bottom is plate 'T3.'
Conclusion: We were able to examine three agar plates and successfully wet-mount and gram-stain each of them in order to learn more about the bacteria living in each plate. The bacteria on plates '2' and '4' were very similar, while the bacteria on plate 'T3' had some differences. For example, 'T3' was the only plate with evidence of rod-shaped bacteria, and was the only plate with fast-moving bacteria. It makes sense that 'T3' would contain different types of bacteria/organisms than the other plates because only certain types of bacteria are antibiotic-resistant (as we learned in procedure 2), so these bacteria would have to contain special qualities that helped them become antibiotic resistant.
Procedure 4: Start PCR Preparation for DNA Sequence Identification
Objective: The objective of the last experiment was to isolate DNA from the bacteria of two nutrient + agar plates and one agar + tetracycline plate, and then use two primer sequences to selectively amplify the 16S rRNA gene. If successful, we will be able to examine this DNA next week to try and determine why some bacteria are antibiotic resistant and some are not.
Steps:
1. My group transferred a single colony of bacteria to 100 micro liters of water in a sterile tube, and incubated this tube at 100 degrees Celsius for 10 minutes.
2. We repeated step 1 for two more tubes. In total, we used one tube from plate '2,' one from plate '4,' and one from plate 'T3' (the last of which was an antibiotic resistant plate).
2. We then placed the three tubes in a centrifuge and turned on the machine.
3. We used 5 micro liters of supernatant in the PCR reaction.
Raw Data: NONE
Conclusion: After finishing the procedure, we had to wait a week in order to determine whether or not the amplification was successful. If it was, we would be able to determine why some bacteria were antibiotic resistant and some were not. A week after that, we would be able to analyze the DNA sequences. --KB
February 8, 2014 Lab 2 Procedures (Identifying Algae and Protists)
Procedure 1: How to Use a Dichotomous Key
Objective: The objective of the first procedure was to be able to observe several species of protists under a microscope and identify them using a dichotomous key. I hypothesized that by observing the size, shape, movement, and colors of the organisms under the microscope, I would be able to use the dichotomous key to correctly identify the different types of protists.
Steps:
1. I prepared a wet mount of the sample containing the protists, making sure to insert the pipette towards the middle of the sample where more protists were more likely to be.
2. I examined the wet mount at 40x magnification and observed several different motile organisms.
3. I located one organism in particular and focused the microscope to 10x to observe it more closely.
4. I followed the instructions of the dichotomous key to match the organism I saw under the microscope to an organism in the key.
5. I located a picture of the protist I thought I had identified to see if it resembled what I was looking at under the microscope.
6. I wrote down the name of the organism, recorded the size, and drew a picture of it (see Figure 2)
7. I repeated steps 3-6 for a different organism (see Figure 2).
8. I repeated steps 3-6 for a different organism (see Figure 2).
Raw Data:
Conclusions: I concluded that though it was difficult to keep track of the different organisms under the microscope because they moved so quickly, I was fairly accurately able to identify three distinct protists using the dichotomous key. I identified a Peranema, a Euplotes, and a Paramecium aurelia (see Figure 2). I will be able to immediately use these skills to observe and identify different protists in the Hay Infusion Culture (Procedure 2). I will also be able to use dichotomous keys in future labs or other experiments that require me to identify different organisms using dichotomous keys. I addressed the objective by accurately using size, shape, color, and other indicators to identify protists.
Procedure 2: Hay Infusion Culture Observations
Question: What kinds of organisms (specifically protists) have been growing in transect three? I hypothesized that by extracting samples from different parts of the hay culture infusion, my group would be able to use the dichotomous key to identify different protists from different niches in the hay culture infusion. My group's observations of organisms in the hay culture should give us valuable insights as to what different species of protozoa live in transect three.
Steps:
1. I made observations of hay culture infusion, including its coloration, smell, and whether or not life like mold or green shoots existed in the liquid (see Lab 2 Information: Observations AND Figure 3).
2. I used a pipette to extract samples from the film on top of the culture and the plant material in the middle. I made a wet mount of each of these samples.
3. My group and I observed three organisms from the sample of the film on top of the hay infusion culture and three organisms from the plant material in the middle of the hay infusion culture.
4. We wrote down the size and name of the different organisms, and drew pictures of them (see Figure 3 and 4). We used this information to try
Raw Data:
Colpidium from Plant Material:
Conclusions: We identified a Colpidium and Pandorina in both samples from the hay infusion culture, implying that these niches were very similar to one another. The film sample had a Paranema sp. and the plant material sample had a Paramecium aurelia, so those two are different. This implies that these protists are common to different kinds of niches, or that the film and plant material niches are very similar. We could infer that the protists we found in the hay infusion culture are similar to the organisms in our transect since the hay infusion came from the transect. Of course, other organisms from the classroom could have entered the culture since we did not have a lid on it. Through our identification of different protists, we answered the question about what kinds of organisms exist in transect three. Again, obtaining even more practice with dichotomous keys will be helpful in future experiments or observations when I am expected to try and identify microorganisms.
Procedure 3: Preparing and Plating Serial Dilutions
Objective: The objective of this procedure was to prepare for the next week's lab by applying the hay infusion culture to agar petri dishes. The colonies would then be able to grow and replicate faster so that we could observe them for our next lab. Applying them to both agar/nutrient petri dishes and agar + tetracycline plates would allow us to determine whether any of the bacteria was antibiotic resistant. We hypothesized that no colonies would grow on the tetracycline plates because the bacteria would not be antibiotic resistant. We also hypothesized that more bacteria would grow on the less diluted plates.
Steps:
1. We marked four tubes of mld sterile broth as 2, 4, 6, and 8 respectively.
2. We then labeled four nutrient + agar plates as 2, 4, 6, and 8. 2 corresponded to 10^-3, 4 corresponded to 10^-5, 6 corresponded to 10^-7, and 8 corresponded to 10^-9. We labeled three tetracycline + agar plates as T3, T5, and T7. T3 corresponded to 10^-3, T5 corresponded to 10^-5, and T7 corresponded to 10^-7.
3. We swirled the hay infusion culture and and extracted 100 microlitres (using a micropipeter), adding this to the tube labeled 2. The solution inside of this tube became 10^-3 because of the 1:100 dilution.
4. We extracted 100 microlitres from tube 2 and added it to tube 4, creating a 10^-4 dilution.
5. We extracted 100 microlitres from tube 4 and added it to tube 6, creating a 10^-6 dilution.
6. We extracted 100 microlitres from tube 6 and added it to tube 8, creating a 10^-8 dilution.
7. We extracted 100 microlitres from tube 2 and aseptically placed it on the surfaces of agar plates 2 and T3.
8. We extracted 100 microlitres from tube 4 and aseptically placed it on the surfaces of agar plates 4 and T5.
9. We extracted 100 microlitres from tube 6 and aseptically placed it on the surfaces of agar plates 6 and T7.
10. We extracted 100 microlitres from tube 8 and aseptically placed it on the surface of agar plate 8.
11. We left the plates to incubate for one week at room temperature, until our next lab.
Raw Data:
Conclusions: Since we left the agar plates to incubate for a week, we could not immediately verify whether or not our hypotheses were correct. After preparing the agar plates, we maintained our predictions that more bacteria would grow on the less diluted plates, and that no colonies would grow on the tetracycline plates. --KB
January 31, 2014 Lab 1 Procedures (Biological Life at AU)
Procedure 1
Objective: The objective of the experiment was to study the Chlamydomonas, Gonium, and Volvox algae of the Volvicine line to see how selective pressures cause the different algae to specialize over time. By analyzing the functional and reproductive specialization of the cells, I predicted that the Chlamydomonas would be the least specialized of the three cells, followed by the Gonium, and that the Volvox would be the most specialized.
Steps: 1. I prepared a slide by using a pipette to drop a single drop of solution containing Chlamydomonas onto a slide. I then covered the slide with a cover slip. 2. I took the prepared slide to a microscope and tried to find a Chlamydomonas cell on the lowest magnification possible (40x), gradually increasing the magnification so I could study it further. 3. I recorded my observations in Table 1, including the number of cells, colony size, and description of any functional or reproductive specialization. 4. I repeated steps 1-3 for the alga Gonium. 5. I repeated steps 1-3 for the alga Volvox.
Conclusions: I determined that my data supported my hypothesis since the Chlamydomonas was unicellular, only 10 micrometers long, and reproduced through isogamy, while Gonium contained between 4 and 32 cells, was 20 micrometers long (though also reproduced through isogamy), and Volvox contained tens of thousands of cells, was between 350 and 500 micrometers in length, and reproduced using oogamy. The Volvox was also visibly more developed than the Gonium or Chlamydomonas as it was spherical in shape and contained anterior and posterior poles of cells. This experiment only involved a few of the algae on the Volvicine line, but there are many more. In future experiments, I will obtain more than the three algae I examined here and compare the differences between the three algae to better observe how selective pressures work.
Procedure 2
Objective: My objective was to observe transect three and prepare a hay infusion culture to be studied at a later date. By obtaining samples from the transect, I hoped to collect organisms that I would later be able to study to better understand that specific transect.
Steps:
1. I observed abiotic and biotic features in transect three (see the section entitled Lab 1 questions above).
2. I sketched a topographical view of transect three (see Figure 1).
3. My group collected a 10 gram sample from the transect that was 50% soil and 50% plant.
4. We returned to the lab and placed the soil/plant sample in a plastic jar with 500mls of deer park water. The final weight was 11.03 grams.
5. We added 0.1 gms of dried milk to the sample and mixed it for about ten seconds.
6. We took the top off and left the jar to sit for a week.
Future Plans: My group successfully observed transect three and created a hay infusion culture that we could observe the next week to see what life forms existed in the sample. We predicted that adding the dried milk to the sample would allow organisms like protists and bacteria to grow so that we could observe them at a later date. Our work mainly involved setting up a future experiment so it did not involve a hypothesis or prediction of any kind. That will come later.
--KB
January 29, 2014 Lab 2 Information (Identifying Algae and Protists) Packet Questions Procedure 2: Hay Infusion Culture Observations
Initial Observations: The liquid is milky and a film floats on the top. It smells dirty, kind of like a sewer. There are grasses throughout most of the liquid and the leaves have settled at the bottom. The sides of the glass show that the water level has dropped within the last week. I see no signs of life on top of the liquid, only the film.
Samples: My group took one sample from the film on top and another from plant material in the middle. The majority of organisms closer to the plant matter are probably heterotrophic and the plants act as a source of food for them. The organisms in the top film of the culture are probably more autotrophic in nature and therefore do not need to be near the plants.
Pictures:
Characterizations: Sample 1 (Film on top): My group found a Colpidium approximately 80 micrometers in length. Colpidium are mobile protozoa that move by using their flagella. We also found a Pandorina, a photosynthetic colony of cells that each have two flagella they use to move, that was about 40 micrometers in length. We also found a 50 micrometer long Paranema Sp. that moves by using one long flagella and are heterotrophic.
Sample 2 (Plant material in middle): My group found another Colpidium here, this time about 60 micrometers long. We also found another Pandorina about 80 micrometers long and fast-moving. Finally, we found a Paramecium aurelia about 120 micrometers long. Paramecium aurelia are mobile protozoa that move by using cilia, and are heterotrophic.
Meeting all Needs of Life: The five needs of life described in the Freeman text are energy, cells, information, replication, and evolution. The Pandorina meets its energy needs through photosynthesizing, receiving its energy from sunlight. Pandorina are made up of multiple cells, approximately 8 to 16. It stores information in its cells' nuclei and replicates both asexually and sexually. Pandorina are part of the Volvicine line that we learned about in our first lab, somewhere between Gonium and Volvox.
Observing for another Two Months: Had we observed the hay infusion culture for another two months, I think that the heterotrophic organisms would have become more dominant since the autotrophic organisms cannot photosynthesize without sunlight. I think this also means that the plants would have become much more broken down since they are the only food source for the heterotrophic organisms.
Selective Pressures: I think the main selective pressure was the absence of sunlight for photosynthetic organisms. The addition of dried milk also may have been more beneficial for some organisms than others, meaning that organisms unable to use the dried milk as a food source would be unable to grow and reproduce as quickly as the other organisms (or at all). --KB
Excellent start. Great descriptions with nice images and analysis of procedures and results. Add new information to the top of the page to move older entries down. Newest entries at the top of the page. SK
January 29, 2014 Lab 1 Information (Biological Life at AU) Packet Questions Procedure 2: Defining a Niche at AU
General Characteristics of Transect Three: Location: American University Campus in between Hughes Hall and Butler Pavilion Topography: low ground cover throughout most of the area with a sidewalk in the upper left side. There are three high bushes in the middle and several low bushes at the very front. There are some high grasses in the upper right hand corner, and two light poles on either side of one of the three high bushes.
Abiotic and Biotic Components of Transect Three: Abiotic Characteristics: 2 metal light poles, litter/garbage, sidewalk, mulch, soil Biotic Characteristics: 2 squirrels, 1 bird, shrubbery, ground cover plant, tall grasses --KB
January 23rd, 2014 Username entered, able to enter date into lab notebook. --KB